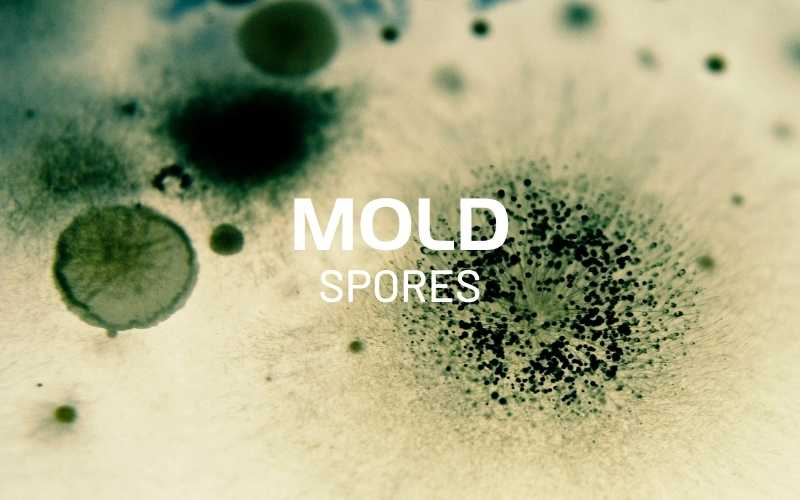

The dangers of mold to humans are well known, but not many people realize that toxic mold can also endanger the health of dogs. Although only a handful of mold species are toxic, the most common type – toxic black mold – can bring serious illnesses and even death to dogs.
Dogs are affected by mold in similar ways to humans. In fact, dogs have a weaker immune system, which makes them more susceptible to mold-related illnesses. Some dog breeds may develop mold allergies faster than others. For instance, brachycephalic breeds (with flat faces and short noses) are prone to respiratory diseases, so exposure to fungus can make it even worse. But in general, all dogs can be affected by mold.

The most common types of fungus in homes are Aspergillus, Cladosporium, and Stachybotrys (or Black Mold). All of these can cause allergic reactions and health problems in humans and dogs. If left untreated, molds can cause serious health problems.
Dogs And Mold Exposure
Pets who are exposed to black mold can experience adverse health effects, including:
- Lung and respiratory issues.
- Damage to the gastrointestinal tract.
- Serious digestive problems.
- Allergic reactions.
- Neurological issues, including tremors and seizures.

Mold’s Favorite Places
Because of its location underground, the basement is a prime spot for water leaks and mold. A recent survey found that 55% of homeowners and renters have lived in a home with a wet basement. But water has ways of getting in that are not immediately obvious and those are the places where mold can thrive. Check these less obvious places for mold in your home:
Cluttered Places
When airflow is blocked by clutter, your heating, ventilation, and air conditioning (HVAC) system can’t properly circulate the air. Condensation can build up on your curtains and vents, creating a moist environment where mold can grow.
Steamy Spaces
Your kitchen, bathrooms, laundry room and other areas that get steamy and humid are problem areas that need proper ventilation fans to remove the damp air.
Dripping Water
Leaky pipes and drips from condensation that forms on pipes and windows create conditions for mold to grow.
Refrigerator Drip Pan
The drip pan is a place where standing water goes unnoticed and undisturbed — the perfect environment for mold growth.
Air Conditioning Ducts
Mold can grow in organic matter, standing water or condensation in your air conditioning ducts. Preventative maintenance can keep mold from growing in your air conditioning system.
Symptoms Of Mold Exposure In Dogs
Signs of mold inhalation in your dog include:
- Respiratory distress (rapid breathing or breathing that takes more effort than usual)
- Nasal discharge
- Coughing, wheezing, sneezing
- Lethargy
- Bleeding from the mouth and/or nose
Some dogs will have an allergic reaction with excessive scratching, chewing or licking that can lead to fur loss and the development of painful sores. If your dog eats mold, it can cause reduced appetite, vomiting and changes in stool.
While the immediate impact of mold is often treatable in the short term, longer term exposure can be more serious and more difficult to manage. When left untreated, mold exposure can lead to organ damage, creating more severe complications.

Symptoms of Dogs Inhaling Mold Spores
Mold spores are all around us – both outdoors and indoors. The types and amount of spores in a given place determines the potential health risk. The amount of airborne mold outdoors varies by season and conditions. People and animals are typically accustomed to the mold types and levels outdoors.
Airborne mold conditions in indoor spaces should be at or below the average amounts observed in the nearby outdoors. Over time, because of moisture, most indoor spaces develop what we call “mold factories,” where mold growth takes place.
Mold factories are typically present in areas where moisture is or was present – i.e. window sills, sinks, bathrooms, toilets, etc. When mold is growing indoors, it’s common for mold to release harmful spores and mycotoxins into the indoor environment.
When unhealthy levels and/or types of mold spores are inhaled by dogs, they can cause a number of health problems, including symptoms like:
- Difficulty breathing
- Wheezing, sneezing, or coughing
- Nasal discharge
- Lethargy
- Nose and/or mouth bleeding
Typically, these symptoms can be successfully treated, but they’ll likely return if the problem environment isn’t corrected. You can prevent your dog from inhaling unhealthy levels of mold spores by controlling the air quality in your home. If you have any moisture problems, you need to resolve them quickly. The EPA suggests having moisture levels in your home between 30-50%. Remember, moisture control is mold control.
Weakened Immunity
As for long-term consequences of mold exposure, dogs can experience aspergillosis, an opportunistic fungal infection. This condition either occurs in the dog’s nasal passages (nasal aspergillosis) or throughout the entire body (disseminated aspergillosis), weakening the dog’s immune system.
Symptoms of nasal aspergillosis include
- Nasal pain
- Bleeding from the nose
- Sneezing
- Nasal swelling
- Reduction in appetite
- Nasal discharge
Animals with disseminated aspergillosis may experience spinal pain, bone inflammation, fever, vomiting, and weight loss. These symptoms generally develop more gradually.
Prevention is the Best Cure
To keep your dog safe from mold, it’s important to remove existing mold and take steps to prevent mold growth.
- Check the underside of hidden areas such as ceiling tiles, drywall, carpets, and wallpaper for mold, since these places can attract and retain moisture. You may be able to remove small areas of mold from solid surfaces with vinegar or baking soda. Be sure to wear gloves and goggles and avoid breathing in mold or mold spores.
- Keep your home’s interior as dry as possible. Repair your leaky basement, roof, pipes, windows, and other areas where water is getting in or accumulates from drips or condensation.
- Ensure that your bathroom and kitchen fans and all ventilation systems are working as they should.
- If water does get in, clean and thoroughly dry the area as soon as possible.
- If you find large areas of mold, you may want to hire professional help to take care of the clean up.
- A K9 Mask® using the N95 Extreme Breathe air filter and even the Clean Breathe air filter in the mask will provide protection for your dog from mold spores.
By taking the above steps you can keep your home a healthy place for you and your furry friend.

Dealing With Mold Sickness In Dogs
There are two components to dealing with mold sickness in dogs. Both are necessary for the successful treatment of your dog and for his return to good health.
The first component is veterinary care. Your vet may prescribe antibiotics, steroids or other medications, depending on your dog’s condition. If your dog is very ill, he may need to stay at the vet’s office for round-the-clock care. Your vet may also recommend against returning your dog to your home until the mold has been removed, since continued exposure to mold can make his illness worse. Be sure to ask your vet if it’s safe to take your dog home.
The second component is mold removal. Remember, mold affects dogs and humans alike. To protect your dog’s health, as well as your own health, you’ll need to remove the mold as quickly as possible from your home.
Some people prefer to hire a mold remediation professional, while others prefer to clean a mold problem in their home themselves. The Environmental Protection Agency recommends hiring a professional if mold covers an area greater than 10 square feet, if you have mold in your heating and air conditioning ducts, if the mold was caused by sewage or contaminated water, or if you yourself have health problems that may be made worse by contact with mold.
It’s important to make sure you remove as much mold as possible from the home and to that end, it’s important to understand that mold often grows in hard-to-spot areas. It is possible, common even, to have mold in multiple locations of the home. If you miss some of the mold, your dog’s health will still be at risk since mold affects dogs so severely. Of course, your own health and the health of other family members will also be at risk.
When Should You Call A Pro?
It’s important to remember that mold infestation often involves more than what meets the eye. If you suspect you have hidden mold, or if the moldy area is too large to clean up with vinegar or baking soda, your safest course of action is to call a professional.
A general contractor or handyman won’t necessarily have the expertise to manage the job. The Environmental Protection Agency (EPA) recommends you “make sure the contractor has experience cleaning up mold.” Be sure that the professionals you hire have experience, can provide references (do check the references!) and are bonded and insured.
Cleaning Black Mold From Your House, a Professional Job?
When you hire a professional to assess the situation and remove mold from your home, expect the process to look something like this:
- First, the company should inspect your home and advise you of the extent of your mold problem. Ask them to provide you with a written schedule (including how much time areas of your home will be unavailable to you), instructions on how to prepare and what to expect. For your own safety, your family will not have access to rooms or areas where the mold cleaning team is working.
- To prevent the mold spores from dispersing into the air, the mold removal specialist will seal off the work area with plastic sheeting. You may have to turn off your heating or air conditioning systems.
- The will remove and discard mold-damaged building materials (drywall, insulation, baseboards, carpeting etc.). Restoration is not typically included as part of the mold clean up.
- In addition to fans and high efficiency particulate air (HEPA) vacuums to remove mold spores, most services use antimicrobial chemicals to clean the mold and the stains. Some services use “green” cleaning solutions but even “green” cleaning product can contain dangerous ingredients. A recent study found that 100 percent of goods labeled “natural,” “organic,” “non-toxic,” or certified as green gave off at least one potentially toxic chemical.
The mold removal service should show you where and how the water is getting in. Remember that moisture is what allows the mold to grow so you will need to take steps to keep the water out in future. Your mold removal company may offer this service or should be able to recommend a provider.
If you suspect your dog is ill due to mold exposure, mention the possibility to your holistic vet. She may not consider the possibility that your dog’s symptoms are due to mold. In addition to treating your dog’s symptoms, be sure to check your home for hidden mold and call a professional if you’re unable to manage the clean up on your own.